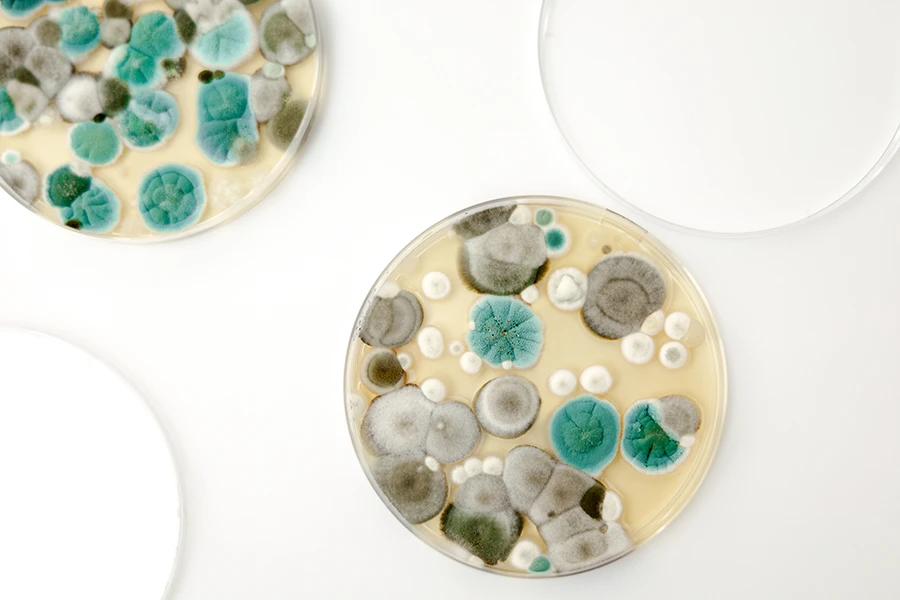
Schimmelpilz

Schimmelpilzsanierung
Gesundes Raumklima durch nachhaltige Schimmelentfernung
Gründliche Beseitigung von Schimmelbefall
Ursachenanalyse und nachhaltige Lösungsvorschläge
TÜV-geprüfte Verfahren für Ihre Sicherheit
Ohne lange Wartezeit: Wir melden uns innerhalb von 48h

Unsere Leistungen gegen Schimmelpilz
Mehr als nur oberflächliche Entfernung
Schimmelbefall beeinträchtigt nicht nur die Optik, sondern vor allem Ihre Gesundheit und die Bausubstanz. Wir entfernen Schimmel fachgerecht, beseitigen die Ursachen und sorgen mit modernen Sanierungsmethoden für eine nachhaltige Lösung.
Dabei setzen wir auf umweltfreundliche und geprüfte Verfahren, die ein dauerhaft gesundes Raumklima schaffen. Damit Ihr Zuhause wieder ein sicherer Ort des Wohlfühlens wird.
Jetzt ausfüllen und ein Angebot erhalten
Ihre Vorteile bei unserer Schimmelpilzsanierung
Warum Sie uns Ihr Zuhause anvertrauen sollten
Nachhaltige Sanierung
Wir entfernen nicht nur den Schimmel, sondern analysieren und bekämpfen auch die Ursache. So können wir der Schimmelbildung langfristig entgegenwirken.
Gesundheitsfreundliche Verfahren
Wir arbeiten mit geprüften und umweltverträglichen Methoden, die vollkommen unbedenklich für Sie und Ihre Haustiere sind.
Ursachenanalyse
Dank unseres Sachverständigen für Schimmelpilzbefall und Feuchteschäden können wir die Ursache eindeutig identifizieren und Ihnen passende Lösungen zeigen.
TÜV-geprüfte Qualität
Wir legen Wert auf saubere Arbeit. Deshalb bekommen Sie bei uns Sicherheit durch kontrollierte Standards und Fachkompetenz.
Schnelle Hilfe
Wir verstehen die Dringlichkeit und bemühen uns deshlab immer um kurzfristige Termine bei akutem Schimmelbefall.
Langfristige Prävention
Nach Abschluss erhalten Sie von uns für Sie geeignete Tipps und Maßnahmen zur Vermeidung erneuten Befalls.
Häufig gestellte Fragen
Bei weiteren Fragen wenden Sie sich direkt an uns
Muss ich während der Sanierung ausziehen?
In vielen Fällen können wir die Sanierung im bewohnten Zustand erledigen. Hierbei entstehen für Sie meinst nur kleine Einschränkungen.
Ist Schimmelpilz gesundheitsschädlich?
Schimmelpilz hat allerogenes Potenzial und jeder Mensch reagiert anders darauf. Hier ist ein Facharzt der richtige Ansprechpartner.
Lässt sich bei einem Streitfall zwischen Mieter und Vermieter die Schuldfrage eindeutig klären?
Als TÜV–Sachverständiger und Mediator kann ich Ihnen hier ebenfalls helfen. Besuchen Sie meine Website:
sachverstand-altmann.de/schimmelpilzbefall

Das sagen unsere Kunden
Über mich
Markus Altmann


Ausgezeichnet mit dem Meisterpreis der bayerischen Staatsregierung
- Sachverständiger für Schäden an Gebäuden & Gebäudeinstandsetzung (TÜV)
- Sachverständiger für Schimmelpilzbefall & Feuchteschäden (TÜV)
- Fachkraft für Wasserschadenbeseitigung (TÜV)
- Maler- & Lackiermeister
Markus Altmann

